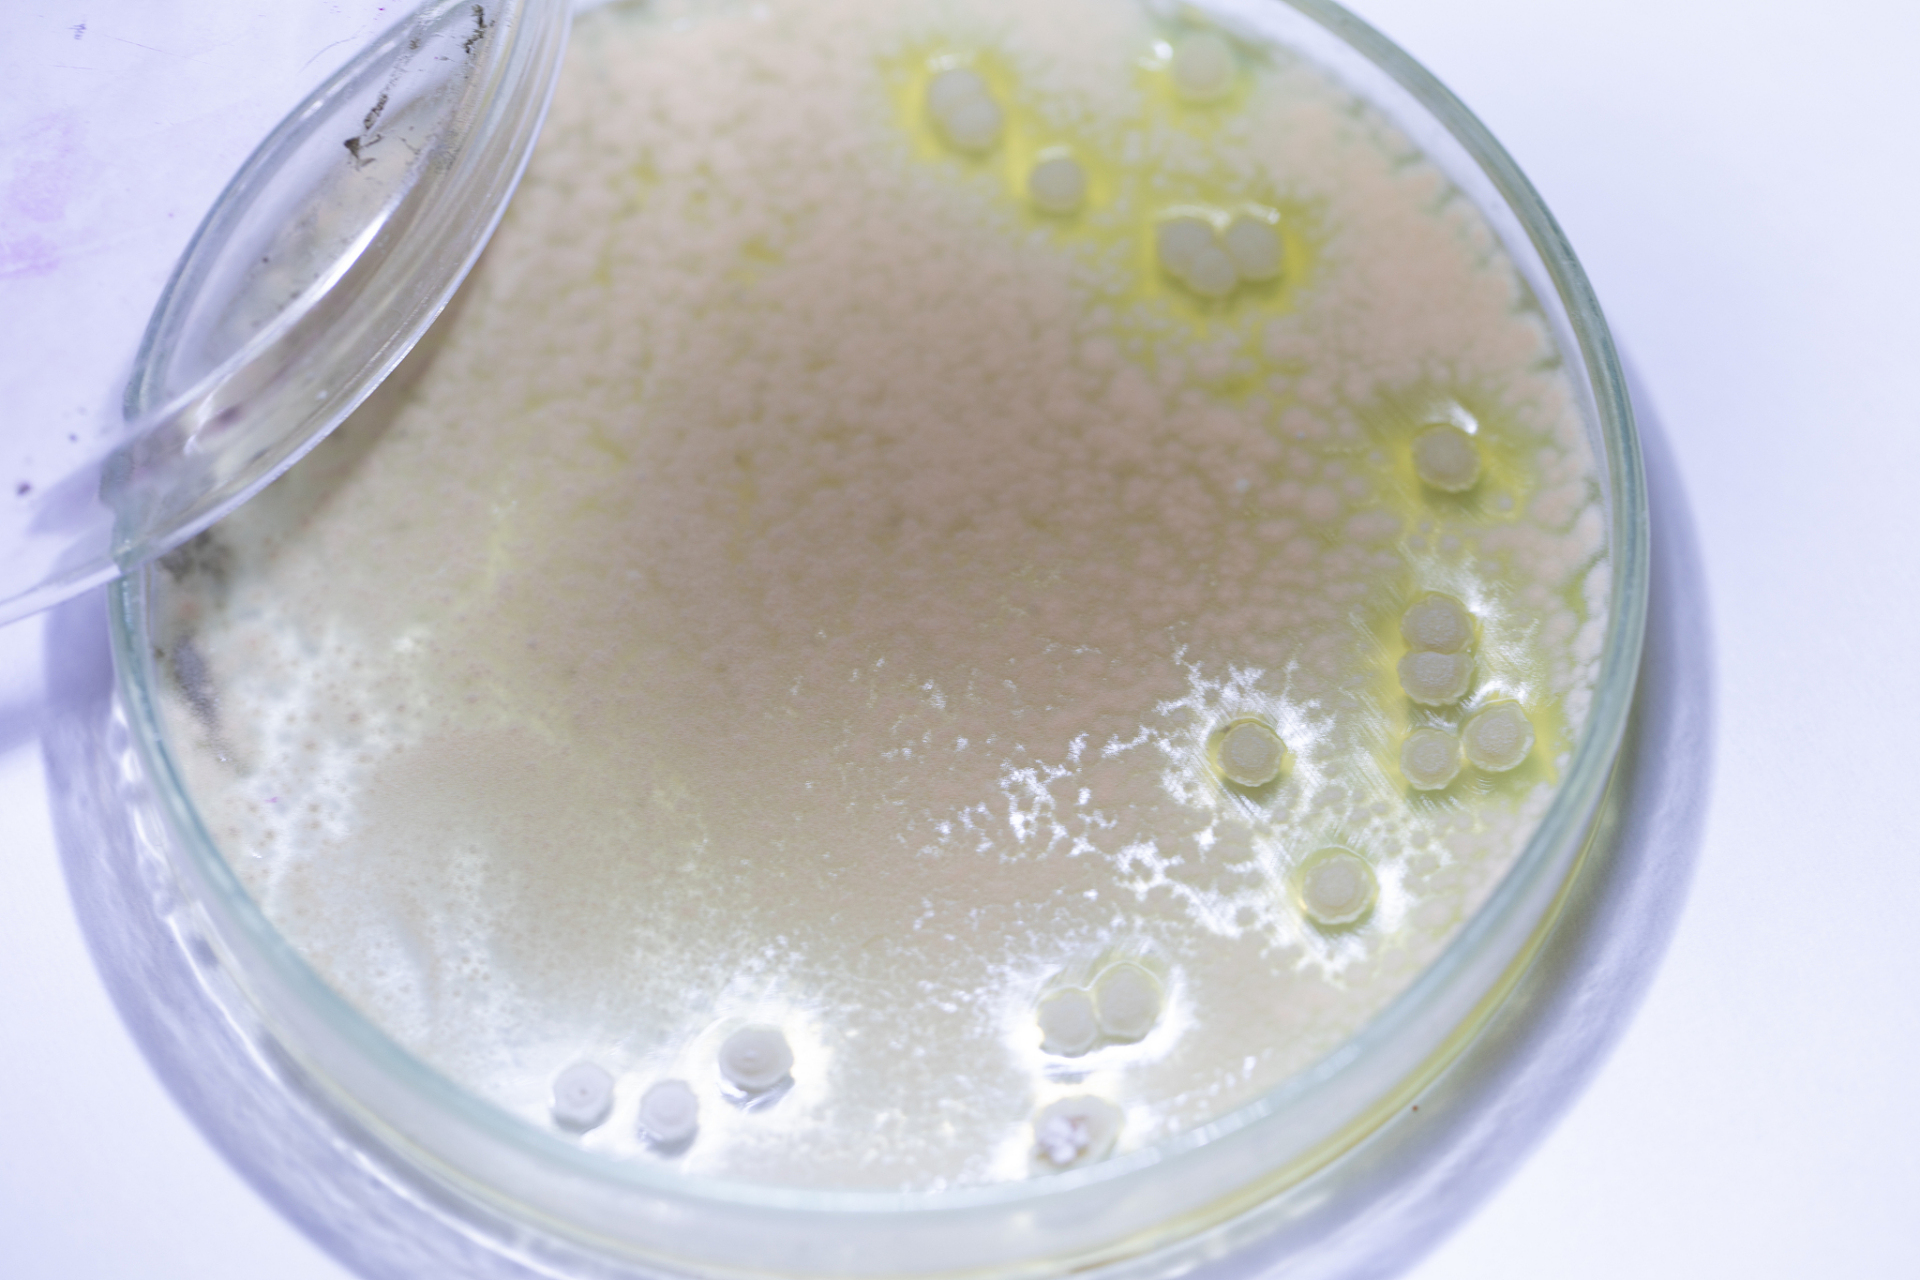
米酵菌酸中毒病死率超50%. #米酵菌酸中毒病死率超五成
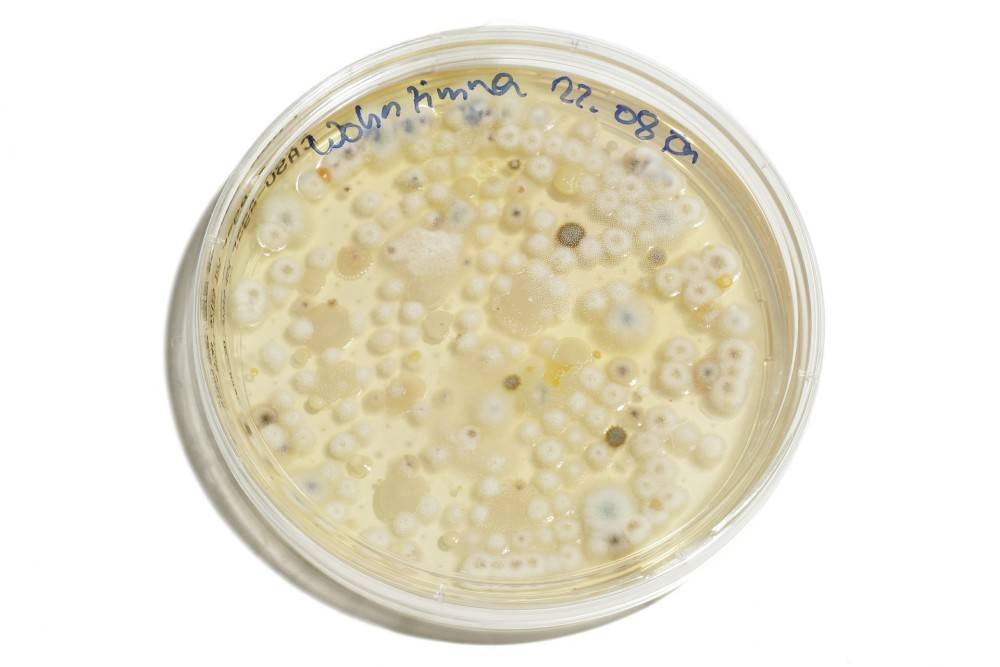
冰箱冻不死费水煮不掉也不是黄曲霉素却吃死7人米酵菌酸咋这么毒

米酵菌酸图片

米酵菌酸是发酵玉米面制品,变质鲜银耳及其它变质淀粉类制品是引起
图片尺寸1920x1280
米酵菌酸中毒病死率超50%. #米酵菌酸中毒病死率超五成
图片尺寸1920x1280
警惕!毒病死率超50%——米酵菌酸!
图片尺寸640x427
【科学辟谣】泡发食物很危险,都会引起米酵菌酸中毒?
图片尺寸800x941
米酵菌酸中毒病死率超 50%,夏季如何避免食物中毒?如何急救?
图片尺寸1080x675
"索命"凉皮中的米酵菌酸,究竟有多危险?
图片尺寸1080x11982
东北酸汤子中毒事件之米酵菌酸
图片尺寸720x681
冰箱冻不死费水煮不掉也不是黄曲霉素却吃死7人米酵菌酸咋这么毒
图片尺寸1000x667
吃了发霉食物导致器官衰竭,黄曲霉素和米酵菌酸,危害如此之大?
图片尺寸1186x668
米酵菌酸
图片尺寸1080x1906
在高温潮湿的天气下,河粉,肠粉等食物容易产生米酵菌酸毒素,而中毒病
图片尺寸640x832
毒性*的米酵菌酸,检测方法这里有!
图片尺寸646x434
米酵菌酸中毒病死率超50%!
图片尺寸642x362
米酵菌酸毒素是一种强烈的毒素,摄入大量的米酵菌酸毒素会导致肝脏
图片尺寸853x1280
【科普】滚开!邪恶的米酵菌酸
图片尺寸520x300
高压蒸煮不能破坏米酵菌酸毒性 要怎么防备?
图片尺寸427x301
致9人中毒身亡的米酵菌酸究竟有多"毒"?专家告诉你
图片尺寸1280x720
高温都杀不死的米酵菌酸到底有多可怕,速转到相亲相爱一家人群!
图片尺寸640x534
"米酵菌酸"这是种什么物质?此物质有什么特点?
图片尺寸620x434
广东发布紧急提醒:慎防米酵菌酸毒素中毒!
图片尺寸831x549